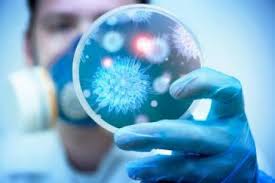

Көкжөтел – екпемен басқарылатын, Bordetella pertussis бактериялары тудыратын тыныс алу жолдарының жұқпалы ауруы.
Көкжөтел спазм тәрізді жөтелмен, интоксикациямен жене тыныс алу жолдарының басым зақымдалуымен сипатталады.
Инфекция көзі және механизмі
Инфекция көзі – науқас адам немесе көкжөтел қоздырғышының тасымалдаушысы. Негізгі эпидемиологиялық қауіп – бұл көкжөтелмен ауыратын адамдар, олардың қоздырғышы инкубациялық кезеңнің соңғы күндерінен басталып, алғашқы клиникалық көріністерден бастап катаральды кезеңде, сондай-ақ спазмодикалық жөтелдің, бірінші аптасында максимумға жетеді. Кішкентай балалар ушін аурудың көзі – көбінесе ересектер немесе үлкен балалар.
Инфекция механизмі – ауа тамшылары. Инфекцияға бейімділік жоғары. Жаңа туылған нәрестелер ерекше қауіп тобына жатады.
Алдын алу шаралары
Бүгінгі таңда белсенді алдын алудың, жалғыз шарасы – вакцинация. Балаларға екпелер 2 айлық жастан бастап препаратты 1 ай аралықпен үш рет енгізеді. 18 айлық және 6 жасында екі реттік ревакцинация жүргізіледі.
Балалардың өмірі мен денсаулығын сақтау үшін күнтізбеге сәйкес вакцинация туралы ұмытпай, оларды жұқпалы ауруларға, әсіресе көкжөтелге қарсы уақтылы егу өте маңызды. Уақтылы вакцинация арқылы балаларыңызды көкжөтел инфекциясынан қорғаңыз!
Жамбыл облысының санитариялық-эпидемиологиялық бақылау департаментінің басшы орынбасары – Мұхаметрахимов Мұрат Алыбекұлы